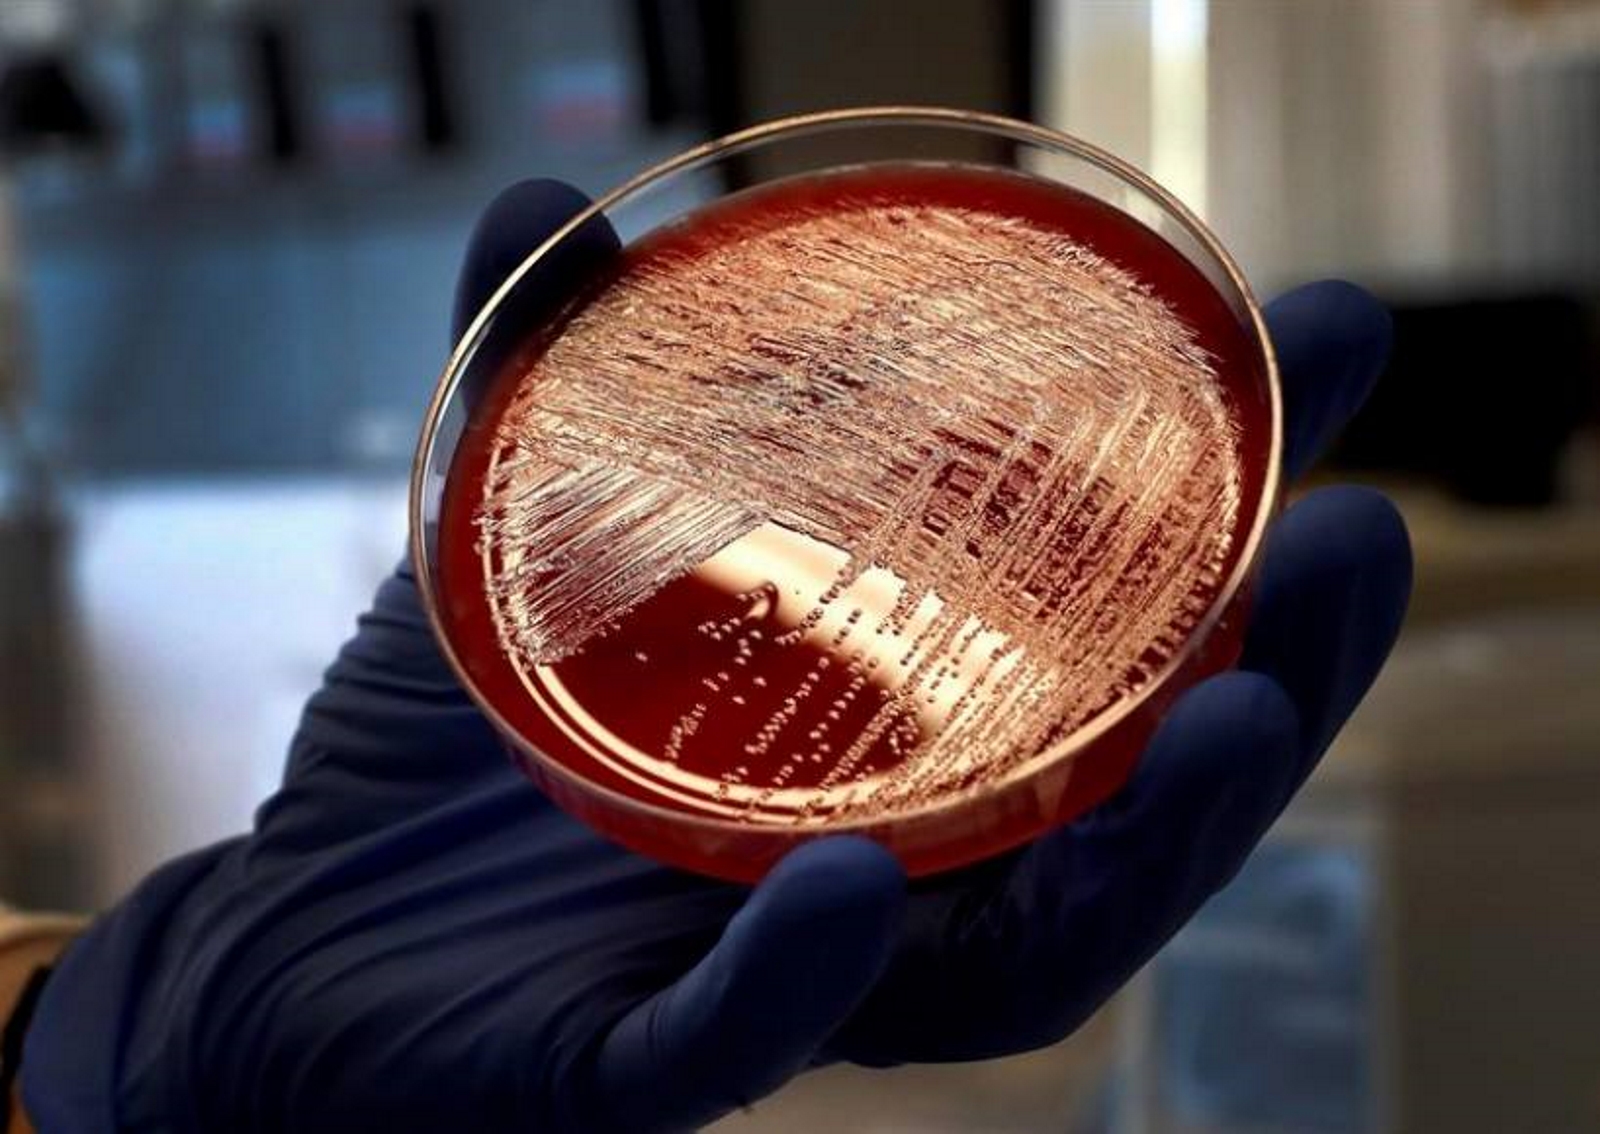
FOTOGRAFÍA. MADRID (ESPAÑA), 12.09.2019. Cultivo de listeriosis en una placa de Petri, Laboratorio de Listeriosis del Centro Nacional de Microbiología de Madrid. Efe

Efe – Los casos confirmados de listeriosis muestran una tendencia «significativamente» al alza en el último lustro tanto en la Unión Europea en general como en España, según el informe del 2018 sobre enfermedades zoonóticas publicado hoy por entes europeos. Roma (Italia), domingo, 29 de diciembre de 2019.
La Agencia Europea de Seguridad Alimentaria (EFSA) y el Centro Europeo para la Prevención y Control de Enfermedades (ECDC) ponen el foco en la listeria, la salmonela y en el virus del Nilo Occidental, que en 2018 septuplicó las infecciones en la Unión Europea (UE).
LISTERIA: En 2018, en la UE el número de casos confirmados por esta bacteria peligrosa y resistente que provoca la listeriosis si se ingiere viva fue de 2.549, mientras que el año anterior fue menor, de 2.479.
Es una variación pequeña, que en Europa afecta a 0,47 de cada 100.000 personas, pero la EFSA advierte de que en cualquier caso esta enfermedad ha mostrado «una tendencia estadística significativamente al alza» en los últimos cinco y diez años.
España no es ajena a esta tendencia y también ha visto aumentar los brotes de listeriorisis. Desde 2014 los casos confirmados en humanos pasaron de los 161 de aquel año a los 206 de 2015, 362 en 2016, 284 en 2017 y los 370 del 2018, según los datos del informe.
Es el segundo país europeo con más casos, después de Alemania (683) y por delante de Francia (338).
Un año después de este informe, en 2019, la listeriosis tuvo un fuerte brote en España por el consumo de carne mechada que se saldó en la región de Andalucía (sur) con tres muertes, siete abortos y más de doscientas personas afectadas.
SALMONELA: Por otro lado la EFSA advierte que la principal causa de brotes de enfermedades causados por los alimentos en la Unión Europea es la salmonela, una bacteria que provoca la salmonelosis y que puede derivar en graves infecciones intestinales y sistémicas.
Los Estados miembro de la UE notificaron el pasado año un total de 5.146 brotes transmitidos por alimentos, principalmente huevos, y en 2018 el número de casos confirmados ascendió a 91.857, sobre todo en Alemania, España, República Checa, Francia, Polonia y Reino Unido.
En España los casos confirmados de salmonelosis en humanos han bajado en los últimos tres años. En 2014 fueron 6.633; en 2015 subieron a 9.015; en 2016 a 9.818 y desde entonces han bajado a los 9.424 casos de 2017 y a los 8.730 del pasado año.
En cualquier caso la salmonelosis fue la segunda infección gastrointestinal más frecuente entre humanos de la UE (91.857 casos reportados), después de los 246.571 de campilobacteriosis.
Y la tendencia de la salmonelosis en humanos se ha estabilizado en los últimos cinco años después de un «largo periodo a la baja».
LA ALERTA DEL VIRUS DEL NILO: La agencia europea también alerta de que «de lejos» el mayor aumento de infecciones de 2018 tuvo que ver con el virus del Nilo Occidental, que puede provocar una enfermedad mortal del sistema nervioso trasmitida por los mosquitos.
En concreto los casos reportados el pasado año (1.605) fueron siete veces mayores que los de 2017 (212) por razones que «aún no se han comprendido», según el científico jefe del Centro Europeo para la Prevención y Control de Enfermedades, Mike Catchpole.
El experto subraya que factores como la temperatura, las lluvias o la humedad influyen en la actividad de los mosquitos y eso ha podido tener algo que ver.
Los países europeos más afectados por este virus han sido Italia (610 casos), Grecia (315) y Rumanía (277), mientras que otros Estados de la zona como República Checa o Eslovenia han registrado en 2018 sus primeros casos desde 2013.
Desde 2014 España no ha tenido ningún caso de infección por este virus.












